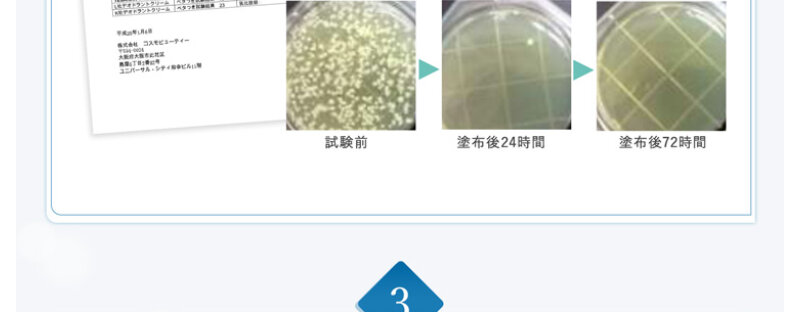
テサラン028

携帯代10,000円て高くない!?格安SIMで月額を半分以下に抑えませんか?
目次
- 格安SIMの選び方3ステップ
- 月に何GB必要か
- 音声SIMかデータSIMか
- 回線の種類を選ぶ
- 【2023年5月】格安SIMおすすめランキング
- 1位:OCN モバイル ONE
- 2位:ワイモバイル
- 3位:UQモバイル
- 4位:LINEMO
- 5位:楽天モバイル
- 6位:y.uモバイル
- 7位:IIJmio
- 8位:mineo(マイネオ)
- 9位:BIGLOBEモバイル
- 10位:HISモバイル
- 【条件別】格安SIMおすすめベストワン
- 端末セット:OCN モバイル ONE
- ドコモ回線:ahamo
- au回線:povo
- ソフトバンク回線:LINEMO
- iPadで使う:IIJmio
- データ無制限:Rakuten UN-LIMIT VII
- 大容量プラン:mineo
- 家族向け:ワイモバイル
- かけ放題:HISモバイル
- 格安SIM人気各社の料金比較表
- 格安SIMの音声SIM料金比較
- 格安SIMのデータSIM料金比較
- 格安SIMのメリット・デメリット
- メリット1:月額料金が安い
- メリット2:テザリングなどのオプションも充実
- メリット3:種類が豊富でキャンペーンが頻繁に開催される
- デメリット1:初期設定は基本的に自分でする
- デメリット2:キャリアメールを持ち運ぶには料金がかかる
- デメリット3:店舗をもたない格安SIMが多い
- デメリット4:混雑時には通信速度が落ちることがある
- 格安SIMに関する独自アンケート
- 乗り換えを検討している格安SIMユーザーは38.6%
- 乗り換え先の人気No.1は楽天モバイル
- 乗り換えない理由の最多は「現状で満足している」
- アンケート詳細情報
- 格安SIMについてよくある質問
- 格安SIMにしたらメールアドレスはどうなる?
- 格安SIMにしても電話番号は引き継げる?
- 格安SIMで5Gは使える?
- 格安SIMにも学割はある?
- 格安SIMでもLINEは使える?
- 格安SIMでも機種変更はできる?
- 格安SIMでガラケーは使える?
- 格安SIMにSMS機能は付けるべき?
- 自分に合った格安SIMを見つけてお得に契約しよう!
格安SIMの選び方3ステップ

格安SIMを選ぶとき、最も重視されるのが「安さ」です。
ほとんどの人が「今より通信費を安くしたい」と考えて、格安SIMへの乗り換えを検討するでしょう。
しかし、コストだけを重視するのはおすすめできません。
通信速度が遅い・購入したスマホが自分に合わないなど、ストレスを感じてしまう可能性があるからです。
コスト面のほかに自分が重視したいポイントを考えてみると、本当に満足できる格安SIMを選べますよ。
ここからは、自分に合った格安SIMを選びための3ステップを紹介します。
格安SIMの選び方 3ステップ
- 月に何GB必要か
- 音声SIMかデータSIMか
- 回線の種類を選ぶ
月に何GB必要か
大手キャリアのような、データを使った分だけ料金が加算される従量制のプランは、格安SIMにはありません。どんなに低容量であろうと基本的には定額制です。
より安く格安SIMを利用したい場合は、自分が普段使うデータ量を、まず把握しておく必要があります。

画像引用元:総務省
上表は、携帯電話の加入プランの割合と、実際に使っているデータ使用量の割合を比較したものです。月に20GB以上使えるプランを選択したユーザーは4割以上になるものの、実際に20GB以上使っているユーザーは約1割。
実際に使っているデータ量にあわせて適切なプランを選ぶことは、簡単なようで難しいことがわかります。
とはいえ、こうなる原因の多くは、自分が使っているデータ量をしっかり把握していないためです。
しっかりと自分が普段使っているデータ量を把握し、自分に合ったプランを選びましょう。
総務省の調査によると…
- 月20GB以上のプラン契約者:42.8%
- 実際に20GB以上使っている人:11.3%
音声SIMかデータSIMか
格安SIMでは、基本的に2種類のSIMを販売しています。格安SIMで販売しているSIM
- 音声SIM:通話とデータ通信ができるSIM
- データSIM:データ通信のみができるSIM
つまり、スマホで電話番号を使った通話を行いたい場合は、必ず音声SIMを選ぶ必要があります。
データSIMは音声SIMより料金が安いため、ついつい手が出そうになってしまいますよね。
しかし、電話番号を使って通話したいのであれば、必ず音声SIMを選びましょう。
一方、サブ用やタブレット用など音声通話が必要ない場合には、格安料金で利用できる「データSIM」がおすすめです。
音声通話が利用できない分料金が安く設定されているため、通話ができないタブレットの運用に最適なSIMといえます。
利用する端末の機能や想定している使い方に合ったSIMを選ぶようにしましょう。
(参考:y.u mobile|音声通話SIMとデータSIMの違いは何?)
回線の種類を選ぶ
格安SIMではドコモ・au・ソフトバンクの回線を使用できます。しかし、格安SIMごとに取り扱っている回線は異なるもの、特定のキャリアの回線を使いたい場合は注意してくださいね。
また利用する端末によって対応しているバンドが異なるため、端末の対応バンドが格安SIMが提供するキャリア回線で使えるかも確認しておく必要があります。
今キャリアを使っているのであれば、同じキャリアの回線を取り扱っている格安SIMへ乗り換えれば、SIMロック解除の手間を省ける可能性が高いです。
また、mineoのようにドコモ・au・ソフトバンクの3社に対応している格安SIMもあります。格安SIM選びの際はチェックしてみましょう。
(参考:総務省|携帯電話ポータルサイト)
【2023年5月】格安SIMおすすめランキング

さっそく、おすすめの格安SIMをランキング形式でご紹介します。
格安SIM選びに迷っている方は、ぜひ参考にしてみてくださいね。
【2023年最新】格安SIMおすすめランキング
- OCN モバイル ONE
- ワイモバイル
- UQモバイル
- LINEMO
- 楽天モバイル
- y.uモバイル
- IIJmio
- mineo(マイネオ)
- BIGLOBEモバイル
- HISモバイル
1位:OCN モバイル ONE

画像引用元:OCN モバイル ONE
| データ量 | 音声SIM | データ+SMS | データ専用 |
|---|---|---|---|
| 500MB | 550円 | – | – |
| 1GB | 770円 | – | – |
| 3GB | 990円 | 990円 | 858円 |
| 6GB | 1,320円 | 1,320円 | 1,188円 |
| 10GB | 1,760円 | 1,760円 | 1,628円 |
| 公式サイト | OCN モバイル ONE公式サイト | ||
OCN モバイル ONEの特徴
- スマホとのセット購入が安い
- プラン料金は格安SIMのなかでも最安級
- 500MBプランは10分の無料通話付き
- 通話料は30秒11円で通常の半額
- 通信速度は比較的良好
格安SIMの中でも特に料金が安く、3GBは990円、10GBは1,760円で利用できます。
さらに500MBプランは10分相当の無料通話付きなので、データ通信はほとんど行わず通話メインで利用したい人にもおすすめです。
ちなみに、OCN モバイル ONEは通話料も安いです。
多くの通信会社では30秒につき22円の通話料がかかりますが、OCN モバイル ONEは半額の30秒11円でかけることができます。
専用アプリも不要で、スマホから発信すると自動的にOCNでんわでの利用となるのも便利です。
通話オプションも利用することができるので、電話をかけることが多い人にもおすすめの格安SIMといえます。
そんなOCN モバイル ONEは、ドコモのエコノミーMVNOということもあり、ドコモショップで契約手続きできるなど他の業者に比べて優れている点が多く見られます。
特に通信速度は、格安SIMながら優秀です。
一般的に格安SIMが苦手とされているお昼休みの時間帯でも、快適に通信できると言われています。
ドコモ回線のまま格安SIMに乗り換えたい人は、ぜひOCN モバイル ONEに乗り換えましょう。
取り扱い機種も豊富で格安で手に入れられる
OCN モバイル ONEはスマホとセットで申し込みも可能です。取り扱い機種が豊富で、使い方に合ったスマホを選ぶことができます。
オンラインショップでは中古スマホも取り扱っているので、人気のiPhoneも格安で手に入れることができますよ。
さらにオンラインショップでは度々セールを開催しており、期間中は対象機種を特別価格で購入することが可能です。
現在は5月8日11時まで人気のスマホSALEを開催しています。
乗り換えの際にスマホの買い替えを検討している人は、ぜひオンラインショップをチェックしてみてくださいね。
2位:ワイモバイル

画像引用元:【公式】ワイモバイル(Y!mobile)
| プラン名 | シンプルS | シンプルM | シンプルL |
|---|---|---|---|
| データ量 | 3GB | 15GB | 25GB |
| 月額料金 | 2,178円 | 3,278円 | 4,158円 |
| 通話料 | 22円/30秒 | ||
| 家族割引 または おうち割光セット |
-1,188円 | ||
ワイモバイルの特徴
- 通信速度が安定
- 5Gに対応
- シンプルM・Lでは速度制限でも最大1Mbps
- くりこし可能
ソフトバンクと同じ通信網を利用しているため、通信速度が安定しているのが魅力。
また、割引サービスを使えることもワイモバイルのおすすめポイントです。
2021年2月18日に開始された料金プランのシンプルM・Lでは、データ容量を使い切って速度制限がかかったとしても、最大1Mbpsで通信できます。
SNSやウェブの閲覧程度なら、大きなストレスを感じることなく利用できるでしょう。
なお、ワイモバイルではあまったデータ量を翌月へ繰り越すことが可能になりました。
くりこし可能な容量は、契約中プランのデータ量分までです。
3位:UQモバイル

画像引用元:【公式】UQ mobile(モバイル)
| 項目 | くりこし プランS+5G |
くりこし プランM+5G |
くりこし プランL+5G |
|---|---|---|---|
| データ容量 | 3GB | 15GB | 25GB |
| 基本料金 | 1,628円 | 2,728円 | 3,828円 |
| 通話料 | 22円/30秒通話オプション ・通話放題:月額1,980円 ・通話放題ライト:月額880円 ・通話パック(60分/月):月額550円 |
||
| 通信方式 | 4G/5G | ||
UQモバイルの特徴
- 通信速度が安定
- 5Gに対応
- auでんきやネットとセットで「自宅セット割」
- くりこし可能
- 節約モードでデータを賢く運用できる
2021年9月2日から5G回線も提供開始しました。
auと同じ通信網を利用しているため、通信品質がよいことに定評があります。
これまであった家族割引はなくなったものの、auでんきやネットとセットで使う場合は下表の「自宅セット割」を適用できます。
| プラン名 | くりこし プランS+5G |
くりこし プランM+5G |
くりこし プランL+5G |
|---|---|---|---|
| 基本料金 | 1,628円 | 2,728円 | 3,828円 |
| 自宅セット割 | -638円 | -638円 | -858円 |
| 合計 | 990円 | 2,090円 | 2,970円 |
さらに「節約モード」も利用できます。
通常の通信速度より低速にはなるものの、データ量は消費されません。
SNSやウェブページの閲覧程度なら十分な速度でしょう。
うまく活用すれば、データ量の消費をグンと抑えられますよ。
UQモバイルアプリからいつでも設定でき、操作も簡単ですよ。
4位:LINEMO

画像引用元:オンライン専用ブランド“LINEMO”
| 項目 | ミニプラン | スマホプラン |
|---|---|---|
| 月額料金 | 990円 | 2,728円 |
| 通信容量 | 3GB LINEギガフリー |
20GB LINEギガフリー |
| 速度制限時 | 300Kbps | 1Mbps |
| 音声通話 | 22円/30秒 通話オプション 通話準定額:月額550円 通話定額:月額1,650円 |
|
| ネットワーク | 4G/5G | |
| 手続き方法 | オンラインのみ | |
| 新規契約事務手数料 | 無料 | |
LINEMOの特徴
- プランは2種類
- 5G対応
- LINEアプリはギガフリー
2021年3月17日にサービスが開始されました。
ソフトバンクと同じ回線を使っています。
そのため、通信速度や安定性はソフトバンクと同レベルです。
料金プランは2種類、2021年7月15日に開始した月額990円で3GB使える『ミニプラン』と、月額2,728円で20GB使える『スマホプラン』です。
どちらも5Gに対応しています。各種事務手数料は無料です。
音声通話料金は30秒で22円かかるものの、無料オプションを提供。
また、LINEアプリ使用時の通信量はギガフリーの対象になります。
そのため、LINEアプリだけで20GB以上のデータを利用することも不可能ではありません。
オンライン専用ブランドのため店頭や電話でのサポートは受けられませんが、その分ワイモバイルよりも格安料金でサービスを提供しています。
オンラインでの手続きに不安がない人は、ぜひLINEMOの利用を検討してみましょう。
オンライン専用ブランド初の留守番電話オプションの提供スタート
LINEMOでは、ユーザーからの要望が多かった留守番電話オプションの提供を開始しました。月額220円で、以下の3つのサービスが利用できます。
留守番オプション
- 留守番電話サービス
- 着信転送サービス
- 着信お知らせ機能
「格安プランで利用したいけど留守番電話サービスが利用できないのは困る」という人は、ぜひLINEMOに乗り換えましょう。
5位:楽天モバイル

画像引用元:楽天モバイル
| Rakuten UN-LIMITVIIの基本情報 | |
|---|---|
| 月額料金 | 0~3GB:1,078円 3GB超~20GB:2,178円 20GB超~無制限:3,278円 |
| 通信容量 | 楽天回線:無制限 パートナー回線:5GB |
| 速度制限時 | 最大1Mbps |
| 音声通話 | 専用アプリ使用で国内通話無料 |
| ネットワーク | 5G・4G |
| 海外 | 67の国々・地域で利用可能 |
| 手続き方法 | オンライン・店舗 |
| 新規契約事務手数料 | 無料 |
| 機種変更手数料 | |
| MNP転出手数料 | |
| 提供開始日 | 2022年7月1日 |
楽天モバイルの特徴
- データ使用量に応じて月額料金が変動
- データ無制限でも月額3,278円と携帯業界最安級
- 専用アプリ「Rakuten Link」利用で国内通話が24時間無料
- 楽天回線エリア(4G)の人口カバー率は98%※2022年10月末時点
旧プランと同じく使用したデータ量に応じて月額料金が変動する方式を採用しており、3GBまで月額1,078円で利用できます。
あまり通信しない人であれば、格安料金で利用することが可能です。
また、たくさん使いたい人も格安で利用できるのが楽天モバイルの最大の魅力です。
20GBを超える通信を行う場合は、月額3,278円で使い放題に。
あまり通信しない人も、たくさん通信したい人も格安料金で利用することができます。
さらに、専用アプリ「Rakuten Link」を利用すれば国内通話も24時間無料でかけ放題。
たくさん電話をかける人にもお得な料金プランです。
現在は自社回線の人口カバー率も98%を達成しており、日本各地で利用することができます。
携帯料金を節約したい人は、ぜひ乗り換えを検討してみましょう。
6位:y.uモバイル

画像引用元:y.u mobile
| 項目 | 月額 | データ容量 | U-NEXT |
|---|---|---|---|
| シングル | 1,070円 | 5GB | × |
| シングル U-NEXT | 2,970円 | 10GB | ○ |
| シェア U-NEXT | 4,170円 | 20GB | ○ |
y.uモバイルの特徴
- 提供プランは3種類
- 1GBにつき330円でデータチャージ可能
- データのくりこしあり
- 音声通話SIM契約で端末の無料補償制度がある
通信量が足りないときは、1GBにつき330円でチャージできます。
また、データが余ってしまった場合は永久にくりこし可能でギガを無駄なく使え、ストック上限は100GBです。
音声通話SIMを利用している場合、無料で年間最大30,000円(非課税)までの修理費用を補償してくれます。
他の格安SIMでは有料オプションになる補償サービスが無料で付いてくるのは魅力的ですよね。
故障のリスクが心配な方は、ぜひチェックしてみてください。
7位:IIJmio

画像引用元:格安SIM/格安スマホ・インターネットサービスのIIJmio
| 項目 | 音声 | SMS | データ | eSIM |
|---|---|---|---|---|
| 2GB | 850円 | 820円 | 740円 | 440円 |
| 5GB | 990円 | 970円 | 900円 | 660円 |
| 10GB | 1,500円 | 1,470円 | 1,400円 | 1,100円 |
| 15GB | 1,800円 | 1,780円 | 1,730円 | 1,430円 |
| 20GB | 2,000円 | 1,980円 | 1,950円 | 1,650円 |
IIJmioの特徴
- 5G対応
- eSIMが使える
- プラン料金が他社よりも比較的安い
- 高速データ通信のON/OFFが可能
2019年7月18日に国内で初めてeSIMプランの取り扱いを開始し、また2021年6月には無料の5Gオプションの提供も開始しました。
2021年4月1日より開始した新料金プラン『ギガプラン』は全体的に他社よりも安いです。
データ量に応じて細かくプランが分かれているので、利用状況に合わせてぴったりなプランを選ぶことができますよ。
さらに2023年4月1日に一部の料金プランが改定され、より安く利用できるようになりました。
月額料金は据え置きのまま4ギガプランは5ギガプランに、8ギガプランは10ギガプランにデータ量が増量しています。
高速データ通信をON/OFF切り替えて利用できるのもポイントです。
高速データ通信をOFFにすると通信速度は最大300kbpsに制限されますが、データ容量を消費せずに通信できます。
必要に応じて使い分けできるので、データ量を節約できて便利です。
8位:mineo(マイネオ)

画像引用元:格安スマホ・SIM【mineo(マイネオ)】
| 項目 | 音声SIM | データSIM |
|---|---|---|
| 1GB | 1,298円 | 880円 |
| 5GB | 1,518円 | 1,265円 |
| 10GB | 1,958円 | 1,705円 |
| 20GB | 2,178円 | 1,925円 |
| 5G通信オプション | 無料 | |
mineoの特徴
- 料金が安く、月額2,178円で20GB使用可能
- オプション追加(無料)で5G通信にも対応
- ドコモ・au・ソフトバンクの回線を使える
- 月額385円のパケット放題Plus追加でデータ無制限
株式会社オプテージが運営しています。
そんなmineoが2021年2月1日から提供している「マイピタ」には、1GB・5GB・10GB・20GBの4つのプランがあります。
20GBを選択しても、たった2,178円!たくさん通信したい方にもおすすめですよ。
さらに月額385円のパケット放題Plusを追加すれば、データ無制限で通信可能に。
※3日間で10GB以上利用すると速度が制限される場合があります。
通信速度は最大1.5Mbpsと通常よりやや遅くなりますが、標準画質なら動画も快適に再生できます。
通信速度にこだわらなければ、低容量プランでもデータ量を気にせず利用できますよ。
回線は、ドコモ・au・ソフトバンクの3キャリアに対応。
5G通信オプションも無料で付けることができます。
mineoはオプションサービスが充実している
mineoでは2023年春から新サービスを提供しており、よりお得に快適に利用できる格安SIMへと進化しました。夜間によく通信を利用する人は、「夜間フリー(月額990円)」がお得です。
加入すると毎日22時半から7時半までの間パケット消費なしで利用することができます。
夜間の利用が多い人は低容量プランに加入し、夜間フリーに申し込めば料金を大幅に節約できますよ。
このように、mineoには他社にはないさまざまなオプションサービスを提供しており、活用すれば料金をグッと安く抑えることが可能です。
mineoに乗り換えの際は、オプションサービスもチェックしてみてくださいね。
9位:BIGLOBEモバイル

画像引用元:ビッグローブ株式会社
| 項目 (音声通話SIM) |
料金 |
|---|---|
| 1GB | 1,078円 |
| 3GB | 1,320円 |
| 6GB | 1,870円 |
| 12GB | 3,740円 |
| 20GB | 5,720円 |
| 30GB | 8,195円 |
| エンタメフリー ・オプション |
308円 |
| 通話料 ※アプリ利用時 |
9.9円/30秒 |
| 10分かけ放題 (通話パック90) |
+913円 |
| 3分かけ放題 (通話パック60) |
+660円 |
BIGLOBEモバイルの特徴
- エンタメアプリがノーカウントになるエンタメフリーオプションが最大の魅力
- 1GB~30GBまで幅広いプランから選べる
- BIGLOBE家族割/ビッグローブ光適用で月220円安く使える
プランは1GB~3GBまでのライトユーザー向けのものから、12GB~30GBまでのヘビーユーザー向けのものまで幅広く提供。
家族でBIGLOBEモバイルを利用またはビッグローブ光とセットで利用すると割引が適用になり、月200円安く利用できてお得です。
さらに、対象のサービスがデータ量の消費ゼロになる「エンタメフリー・オプション」を提供。
YouTubeやABEMAなど、全21種類のサービスがデータ量を気にせず楽しめます。
対象サービスを良く利用する人は、通信量を大幅に節約できますよ。
10位:HISモバイル

画像引用元:国内向けプラン(自由自在290プラン) | HISモバイル
HISモバイルでは、2022年5月19日より新プラン「自由自在290」の提供を開始しました。| 項目 (音声通話SIM) |
料金 |
|---|---|
| 1GB | 550円 ※100MB未満の月は290円 |
| 3GB | 770円 |
| 7GB | 990円 |
| 20GB | 2,190円 |
| 50GB | 5,990円 |
| 通話料 | 9円/30秒通話オプション ・5分かけ放題:500円 ・完全かけ放題:1,480円 |
HISモバイルの特徴
- 1GBプランは月額550円の格安で利用できる
- 1GBプラン契約でデータ使用量が100MB未満の月は月額料金は290円
- 通話料が30秒9円で安い
知名度はあまり高くありませんが、ドコモ回線を利用しているため高品質で安定した通信で利用できます。
新プラン「自由自在290」は業界最安値の料金を実現。
1GBを契約の場合、月のデータ使用量が100MB未満だった場合は月額290円で利用できます。
スマホでほとんどモバイル通信を行わない人に最適なプランといえるでしょう。
さらに通話料も30秒9円と安く、専用アプリなしで利用できるのも利点です。
通話オプションを付けることもできるので、通話メインで使用する人にもおすすめです。
【条件別】格安SIMおすすめベストワン
ここからは、それぞれの条件別にベストな格安SIMを解説していきます。『ドコモ回線がいい』『大容量がいい』など、こだわり別に紹介します。
【条件別】格安SIMおすすめベストワン
- 端末セットがお得
- ドコモ回線
- au回線
- ソフトバンク回線
- iPadにおすすめ
- データ無制限
- 大容量プラン
- 家族・シェア向け
- 通話かけ放題
端末セット:OCN モバイル ONE

| データ量 | 音声SIM | データ+SMS | データ専用 |
|---|---|---|---|
| 500MB | 550円 | – | – |
| 1GB | 770円 | – | – |
| 3GB | 990円 | 990円 | 858円 |
| 6GB | 1,320円 | 1,320円 | 1,188円 |
| 10GB | 1,760円 | 1,760円 | 1,628円 |
理由は端末のラインナップの豊富さにあります。
取り扱っている機種は約30機種以上とキャリア並み。
格安SIMお得意のミドルスペックスマホはもちろん、iPhone 13シリーズなどのハイスペックスマホも販売しています。
また、キャンペーン期間中は、思いもよらぬ機種を1円で購入できることも!
中古iPhone・中古スマホも取り扱っているので、スマホをできるだけ安く手に入れたい人にもおすすめの格安SIMです。
スマホとセットで格安SIMを契約したい場合は、OCN モバイル ONEを検討してみてください。
ドコモ回線:ahamo

| アハモの基本情報 | |
|---|---|
| 月額料金 | 2,970円 |
| 通信容量 | 月間20GBahamo大盛り(+80GB):月額1,980円 |
| 速度制限時 | 最大1Mbps |
| 音声通話 | 1回あたり5分以内の国内通話無料 5分超過時は22円/30秒 |
| ネットワーク | ドコモの5G・4G |
| 海外 | 82の国々・地域で利用可能 |
| 手続き方法 | オンライン・専用アプリ |
| 新規契約事務手数料 | 無料 |
| 機種変更手数料 | |
| MNP転出手数料 | |
| 提供開始日 | 2021年3月26日 |
おすすめの理由は、1回5分以内の国内無料通話&月間20GBで月額2,970円という安さにあります。
今や20GBで2,000円台のプランはいくらでも存在しますが、無料通話付きのものはahamoくらいしかありません。
電話をよくかけるなら、ドコモのahamoは非常におすすめですよ。
さらに、2022年6月9日より「大盛りオプション」の提供を開始。
+1,980円で80GBのデータ量を追加でき、合計で100GBまで利用できます。
20GBを超える通信を行いたい人にも利用しやすくなりました。
また、ドコモ5Gにも対応しており、エリア内であれば高速データ通信が行えます。
海外でもそのまま利用できますし、手数料がすべて無料である点も魅力です。
契約などの手続きは、公式Webサイトやアプリ、ドコモショップ(1回3,300円)で行えます。
圧倒的安さ!20GBで月額2,970円
au回線:povo

| povo2.0の基本情報 | |
|---|---|
| 月額料金 | 0円 トッピングで追加可能 |
| 通信容量 | ~150GB |
| 速度制限時 | 最大1Mbps |
| 音声通話 | 22円/30秒 トッピングで追加可能 1回あたり5分以内の国内通話無料:月額550円 国内通話かけ放題:月額1,650円 |
| ネットワーク | auの4G・5G |
| 海外 | 提供予定(開始時期は未定) |
| 手続き方法 | オンラインのみ |
| 新規契約事務手数料 | 無料 |
| 機種変更手数料 | |
その後2021年9月29日に『povo 2.0』へ料金プランがリニューアルしました。
サービスの自由度が高く、非常に使い勝手の良いプランですよ。
povoは、基本の月額料金が0円です。
そこから、自分にあったデータ量を選んで「トッピング」していくことになります。
「0円」状態のままではデータ通信が行えず、通話しかできないので気を付けてくださいね。
| データ追加容量 | 期間 | 金額 |
|---|---|---|
| 無制限 | 24時間 | 330円 |
| 1GB | 7日間 | 390円 |
| 3GB | 30日間 | 990円 |
| 20GB | 30日間 | 2,700円 |
| 60GB | 90日間 | 6,490円 |
| 150GB | 180日間 | 12,980円 |
それぞれ有効期間も異なるため、自分に合っているものを慎重に選びましょう。
もし迷ってしまった場合は、ライトユーザーの方なら3GBの990円、ヘビーユーザーの方なら20GBの2,700円がおすすめです。
なお、5Gにはもともと対応しているため、別途オプションに加入する必要はありません。
ソフトバンク回線:LINEMO

| 項目 | ミニプラン | スマホプラン |
|---|---|---|
| 月額料金 | 990円 | 2,728円 |
| 通信容量 | 3GB LINEギガフリー |
20GB LINEギガフリー |
| 速度制限時 | 300Kbps | 1Mbps |
| 音声通話 | 22円/30秒 通話オプション 通話準定額:月額550円 通話定額:月額1,650円 |
|
| ネットワーク | 4G/5G | |
| 手続き方法 | オンラインのみ | |
| 新規契約事務手数料 | 無料 | |
ライトユーザーなら3GB(990円)、ヘビーユーザーには20GB(2,728円)がおすすめ。
LINEアプリはギガフリーになります。SNS好きにはかなり魅力的なプランではないでしょうか。
音声通話料金は30秒で22円ですが、無料オプションも提供しています。
また、各種事務手数料も無料です。
使用している回線はソフトバンクと同じものなので、「安いから遅い」ということはありません。5Gにも対応しています。
iPadで使う:IIJmio

| 項目 | 音声 | SMS | データ | eSIM |
|---|---|---|---|---|
| 2GB | 850円 | 820円 | 740円 | 440円 |
| 5GB | 990円 | 970円 | 900円 | 660円 |
| 10GB | 1,500円 | 1,470円 | 1,400円 | 1,100円 |
| 15GB | 1,800円 | 1,780円 | 1,730円 | 1,430円 |
| 20GB | 2,000円 | 1,980円 | 1,950円 | 1,650円 |
新プランの登場により、格安SIMのなかでも最安値級の料金体系になりました。
中でもデータ通信専用のeSIMが破格の安さです。なんと月間20GBで1,650円!
eSIM対応のiPadを利用するなら、IIJmioのeSIMを検討してみてはいかがでしょうか。
データ無制限:Rakuten UN-LIMIT VII

| Rakuten UN-LIMITVIIの基本情報 | |
|---|---|
| 月額料金 | 0~3GB:1,078円 3GB超~20GB:2,178円 20GB超~無制限:3,278円 |
| 通信容量 | 楽天回線:無制限 パートナー回線:5GB |
| 速度制限時 | 最大1Mbps |
| 音声通話 | 専用アプリ使用で国内通話無料 |
| ネットワーク | 5G・4G |
| 海外 | 67の国々・地域で利用可能 |
| 手続き方法 | オンライン・店舗 |
| 新規契約事務手数料 | 無料 |
| 機種変更手数料 | |
| MNP転出手数料 | |
| 提供開始日 | 2022年7月1日 |
理由は簡単、データ無制限で3,000円台なのは楽天モバイルだけだからです。
ドコモ・au・ソフトバンクにもデータ無制限のプランはありますが、月額7,000円台です。
楽天モバイルの安さが際立ちますね。
しかも、楽天モバイルは自社で回線を持っているキャリアですから、通信品質もハイレベル。
専用アプリを使えば国内通話も24時間無料でかけられます。
無制限プランを使いたい方は、楽天モバイルを試してみてはいかがでしょうか。
大容量プラン:mineo

| 項目 | 音声SIM | データSIM |
|---|---|---|
| 1GB | 1,298円 | 880円 |
| 5GB | 1,518円 | 1,265円 |
| 10GB | 1,958円 | 1,705円 |
| 20GB | 2,178円 | 1,925円 |
| 5G通信オプション | 無料 | |
その理由は、10GB以上のプランが安いため。
10GBを1,958円、20GBを2,178円で使えます。
20GBの料金はahamoやpovo、LINEMOよりも安いため、より安さを求めるならmineoが最有力候補となるでしょう。
さらに5月31日までに新規で契約すればキャンペーンが適用になり、月額料金が4ヶ月間1,188円も割引になります。
キャンペーン適用中は20GBプランがたったの990円で利用できます。
mineoへの申し込みは5月中がおすすめですよ。
家族向け:ワイモバイル

| プラン名 | シンプルS | シンプルM | シンプルL |
|---|---|---|---|
| データ量 | 3GB | 15GB | 25GB |
| 月額料金 | 2,178円 | 3,278円 | 4,158円 |
| 通話料 | 22円/30秒 | ||
| 家族割引 または おうち割光セット |
-1,188円 | ||
ワイモバイルなら月額1,188円の家族割引が使えます。
ドコモなどのキャリアではお馴染みの「家族割」。
しかし、格安SIMにおいては非常にレアなサービスです。
ワイモバイルのライバルにあたるUQモバイルは、2021年に家族割を廃止しました。
そのため、今でも家族割を提供しているワイモバイルはとても貴重な存在と言えます。
家族割を使えば、シンプルSが月額990円になるため、月々の負担が非常に軽くなりますね。
もちろん他の家族の料金も値引きされます。
家族で格安SIMを利用する場合は、ワイモバイルを検討してみてはいかがでしょうか。
かけ放題:HISモバイル

HISモバイルの通話オプション
- 5分かけ放題オプション:月額550円
- 完全かけ放題オプション:月額1,480円
かけ放題オプションは2種類から選ぶことができ、他の格安SIMよりも低料金で提供しています。
完全かけ放題オプションを付ければ、通話料を気にせず電話をかけることができますよ。
また専用アプリを必要とせず、通話料が30秒9円と格安なのも魅力です。
通話オプションを付けていなくても通話料が安いので、急に電話をかけることがあっても安心です。
ドコモの高品質な通信を利用しているため、通話品質も安定しています。
格安SIM人気各社の料金比較表

これまでにおすすめしてきた10社の格安SIMの料金を、音声SIMとデータSIMに分けて比較してみましょう。
格安SIMの音声SIM料金比較
最新の料金プランをチェックし、ご自身に合った格安SIMを選びましょう。
格安SIMのデータSIM料金比較
eSIMを利用した場合、上表の料金になります。他社よりも明らかに安いですよね。
大容量帯では、楽天モバイルが他社を圧倒しています。
データ無制限で月額3,278円というコスパの高さは、やはり強いですね。
格安SIMのメリット・デメリット

ここからは格安SIMを契約する前に知っておきたい、格安SIMのメリット・デメリットを紹介していきます。
格安SIMへの乗り換えを検討している方は、手続きをする前にチェックしておきましょう。
メリット
- 月額料金が安い
- テザリングなどのオプションも充実
- 種類が豊富でキャンペーンが頻繁に開催される
デメリット
- 初期設定は基本的に自分でしなくてはいけない
- キャリアメールを持ち運ぶには料金がかかる
- 店舗を持たない格安SIMが多い
- 混雑時には通信速度が落ちることがある
メリット1:月額料金が安い
正直なところ、格安SIMのメリットはこれ一点といっても過言ではありません。名称通り、格安SIMは本当に月額料金が格安です。
デメリットが気にならない人にとっては「格安SIM以外考えられない」と思ってしまうほどです。
大手キャリアで毎月8,000円だった月額料金が、格安SIMでは1,000円や2,000円で済みます。
そのため毎月6,000円、1年に換算すると7万円以上お得になるということになります。
参考:総務省|「モバイル市場の公正な競争環境の整備に向けたアクション・プラン」の進捗状況
毎月の出費を抑えたいなら、格安SIMは本当におすすめですよ。
メリット2:テザリングなどのオプションも充実
格安SIMだからといってオプションが少ないわけではありません。格安SIMでは大手キャリア同様、テザリングが無料で使えます。
テザリングの他にも、国際ローミングやくりこしサービスなど、大手キャリアに引けを取らないサービスが充実しています。
さらにデータ節約モードや、カウントフリーサービスなど、大手キャリアにはない格安SIM独自のオプションがあるのも魅力。
自分に合った格安SIMを選ぶことができれば、安く快適に利用できるでしょう。
メリット3:種類が豊富でキャンペーンが頻繁に開催される
多くの格安SIMでは、「乗り換えで端末が実質0円」「端末が割引で1円」「契約手数料実質0円」などのキャンペーンを定期的に開催。そのため、初期費用を抑えて乗り換えができます。
キャンペーンをうまく活用すれば、端末代金がかからずスマホを使い続けられます。
今や格安SIMは全てネットで申し込みできるため、慣れてくると乗り換えの手続きも難なく可能です。
このように、上手にキャンペーンを利用しながら乗り換えを続けて、タダ同然でスマホを使っていくのも一つの手ですよ。
デメリット1:初期設定は基本的に自分でする
基本的に格安SIMはオンラインで契約手続きを行います。そして、自宅にSIMカードが届いたら、自分で初期設定をしなくてはなりません。
もちろんSIMカードにはマニュアルが同梱されていますし、操作もそこまで難しいものではありません。
とはいえ、スマホ初心者には敷居が高い作業となるので、覚悟しておきましょう。
デメリット2:キャリアメールを持ち運ぶには料金がかかる
ドコモ・au・ソフトバンクには、それぞれのキャリアが提供しているメールアドレスがありますよね。「○○@docomo.ne.jp」などのアドレスです。
ところが、格安SIMに乗り換えるとこれらのキャリアメールは使えなくなってしまいます。
格安SIMに乗り換え後もキャリアメールを継続して利用したい場合は、キャリアが提供しているメール持ち運びサービスの申し込みが必要です。
月額330円の有料サービスとなるため、使い続ける限り料金がかかってしまう点に注意してください。
また、ほとんどの格安SIMでは独自のメールサービスを提供していません。
格安SIMでキャリアメール以外のメールサービスを利用するには、GmailやYahoo!メールなどのフリーメールを自分で取得して利用する必要があります。
デメリット3:店舗をもたない格安SIMが多い
ドコモ・au・ソフトバンクは、全国に2,000以上の店舗を持っています。一方、格安SIMでこれほどの店舗数を抱える業者は一握りです。
そのため、手続きのほとんどがWeb上で行われます。
ただし、UQモバイルとワイモバイルは例外です。
この2社は店舗数がとても充実しています。
ワイモバイルはソフトバンクと、UQモバイルはauと同じ建物に店を構えているケースも多いですね。
そのため、実店舗で店員さんのサポートを受けたい方は、UQモバイルかワイモバイルを選ぶとよいでしょう。
デメリット4:混雑時には通信速度が落ちることがある
格安SIMは大手キャリアから回線を借りているため、ユーザーが一度に接続すると通信制限がかかる恐れがあります。たとえば、携帯を使うことの多いお昼時や周りに人が密集している満員電車などが該当します。
おすすめランキングを参考にして、速度の速い格安SIMを選びましょう。
(参考:LinksMate|格安SIMの会社ごとに通信速度が異なる秘密を解説します!)
格安SIMに関する独自アンケート

スマホメディアbitWaveは、2021年3月24日〜3月25日の期間、格安SIM利用者500人を対象にアンケートを実施しました。
ここからはそのアンケート結果である「格安SIM利用者動向 2021年4月」を紹介します。
※複数回線を契約している場合は、メインの1回線をアンケートの対象としています。
※本調査ではワイモバイル・UQモバイルも「格安SIM」として取り扱っています。
乗り換えを検討している格安SIMユーザーは38.6%
格安SIM利用中の男女500人に「この春、他社への乗り換えを検討しているか」を質問しました。その結果、検討していると答えたユーザーは38.6%でした。

乗り換え先の人気No.1は楽天モバイル
乗り換えを検討していると回答した193人に、具体的に検討している会社・料金プランについて質問。楽天モバイルへ乗り換えを検討していると回答した人(n=83)は最も多く43.0%でした。
次いでahamoを検討してる人(n=48)は24.9%、povoを検討している人(n=14)は7.3%という結果がでています。

MVNO各社への乗り換え検討は比較的少なく、MNOへの流出傾向が浮き彫りになりました。
乗り換えない理由の最多は「現状で満足している」
格安SIMからの乗り換えを検討していないと回答した人(n=307)に、その理由について質問しました。その結果は、「現状で満足している」と答えた人(n=207)が最多の67.4%。
次いで「手続きが面倒」と答えた人(n=74)が24.1%です。

また「各社の料金プランが出揃ってから検討したい」など、現時点の情報だけでは決めきれず乗り換えに慎重になる声もありました。
アンケート詳細情報
- 調査期間:2021年3月24日〜3月25日
- 有効回答:500人
- 調査方法:インターネット調査
- 調査対象:格安SIMを契約している10代〜60代の男女


格安SIMについてよくある質問

格安SIMにまつわる、よくある疑問点とその回答をまとめました。
乗り換え前の疑問をここで晴らしておきましょう。
格安SIMについてよくある質問
- 格安SIMにしたらメールアドレスはどうなる?
- 格安SIMで5Gは使える?
- 格安SIMにも学割はある?
- 格安SIMでもLINEは使える?
- 格安SIMでも機種変更はできる?
- 格安SIMにSMS機能は付けるべき?
格安SIMにしたらメールアドレスはどうなる?
一部の格安SIMでは、独自のメールアドレスを提供しています。独自のメールサービスを提供している格安SIM
- OCN モバイル ONE
- ワイモバイル
- UQモバイル
- 楽天モバイル
- mineo
なお、大手キャリアから格安SIMに乗り換える場合は、「メール持ち運びサービス」に申し込めば引き続きキャリアメールを利用可能です。
月額料金は発生してしまいますが、キャリアメールが使えなくなるのは困るという人は申し込みを検討しましょう。
格安SIMにしても電話番号は引き継げる?
乗り換え元のキャリアでMNP予約番号を取得した後に乗り換えれば、電話番号を引き継げます。この番号を発行しないまま格安SIMと新規契約した場合は、電話番号の引き継ぎができないため注意してください。
ただし、大手キャリアが提供する格安ブランドに変更の際はMNP予約番号は不要です。
MNP予約番号不要で電話番号を引き継げるケース
- ドコモ↔ahamo
- ソフトバンク↔ワイモバイル↔LINEMO
- au↔UQモバイル/au↔povo
※UQモバイル↔povo間はMNP予約番号が必要です。
格安SIMで5Gは使える?
2023年5月現在、以下の格安SIMで5Gが使えます。| 格安SIM | 5G対応 |
|---|---|
| OCN モバイル ONE | 〇 |
| ワイモバイル | 〇 |
| UQモバイル | 〇 |
| LINEMO | 〇 |
| ahamo | 〇 |
| povo | 〇 |
| 楽天モバイル | 〇 |
| y.uモバイル | × |
| IIJmio | 〇 |
| mineo | 〇 |
| BIGLOBEモバイル | 〇※タイプDのみ対応 |
| HISモバイル | × |
格安SIMなら5Gも格安料金で使えるのでお得ですね。
ただし、オプション申し込みや切り替え申し込みが必要な格安SIMもあるので注意してください。
格安SIMにも学割はある?
学割という名称ではありませんが、18歳以下の人を対象にした割引サービスを提供しているところもあります。本記事で紹介した格安SIMの中では、「ワイモバイル」と「UQモバイル」で提供しています。
どちらの学割も、18歳以下の利用者だけでなく家族も割引の対象となるため、家族みんなで乗り換えるとさらにお得です。
学割の詳細については、本記事でも詳しく解説していますので参考にしてみてください。
格安SIMでもLINEは使える?
格安SIMでもLINEの利用はできますが、年齢認証ができない格安SIMでは「ID検索」などの一部の機能は利用できません。このような制限を受けたくない場合は、年齢認証ができる格安SIMを選ぶようにしましょう。
LINEの年齢認証は楽天モバイルを含めた4キャリアと次の格安SIMが対応しています。
年齢認証のできる格安SIM
- ワイモバイル
- UQモバイル(くりこしプラン+5Gのみ)
- mineo
- IIJmio
- イオンモバイル
格安SIMでも機種変更はできる?
格安SIMでも機種変更は可能です。しかし、格安SIMのスマホラインナップは大手キャリアほど豪華ではありません。
扱っているスマホの多くはミドルスペックです。
できるだけたくさんの機種の中から購入するスマホを選びたい方には、取り扱い機種が豊富なOCN モバイル ONEをおすすめします。
格安SIMでガラケーは使える?
4G LTEに対応しているガラケーなら、格安SIMで使うことが可能です。ただし、ケータイ専用プランを提供している格安SIMはありませんので、スマホと同じ料金プランを利用することになります。
ガラケーだから安く使えるといったメリットはありません。
格安SIMならスマホも安く手に入れられるので、ぜひスマホに買い替えを検討しましょう。
格安SIMにSMS機能は付けるべき?
ここ最近は、2段階認証にSMSが用いられる機会が増えてきました。SMS機能がなくても2段階認証できるサービスもありますが、操作が非常に複雑になります。
そのため、データSIMを契約する際は極力SMS機能は付けるべきでしょう。
自分に合った格安SIMを見つけてお得に契約しよう!

2023年5月最新のおすすめ格安SIM10社の料金やサービスについて解説してきました。
【2023年最新】格安SIMおすすめランキング
- OCN モバイル ONE
- ワイモバイル
- UQモバイル
- LINEMO
- 楽天モバイル
- y.uモバイル
- IIJmio
- mineo
- BIGLOBEモバイル
- HISモバイル
使い方に合った格安SIMを利用すれば、年間7万円以上節約することもできるので、毎月のスマホ代を節約したい人は格安SIMへの乗り換えがおすすめです。
ただし、コストだけを重視するのではなく、速度やサービスなども含めて総合的に判断することが大切です。
今回紹介した選び方のポイントなどを参考に、自分の使い方に合った格安SIMを探してみてくださいね。